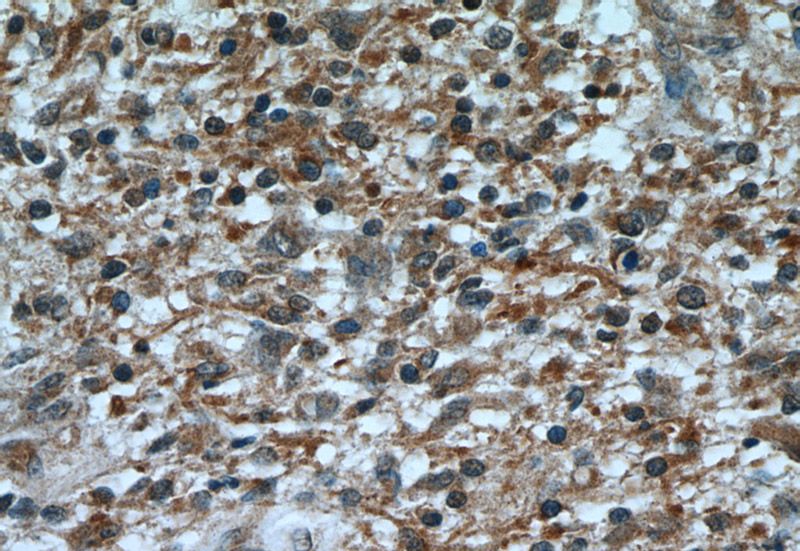
Immunohistochemical of paraffin-embedded human gliomas using Catalog No:113115(NES antibody) at dilution of 1:50 (under 40x lens)

-
Product Name
Nestin antibody
- Documents
-
Description
Nestin Rabbit Polyclonal antibody. Positive IHC detected in human gliomas tissue, mouse brain tissue. Positive IF detected in U-251 cells, SH-SY5Y cells. Positive WB detected in rat brain tissue. Observed molecular weight by Western-blot: 170-180 kDa
-
Tested applications
ELISA, WB, IHC, IF
-
Species reactivity
Human,Mouse,Rat; other species not tested.
-
Alternative names
FLJ21841 antibody; Nbla00170 antibody; NES antibody; nestin antibody
-
Isotype
Rabbit IgG
-
Preparation
This antibody was obtained by immunization of Peptide (Accession Number: NM_006617). Purification method: Antigen affinity purified.
-
Clonality
Polyclonal
-
Formulation
PBS with 0.02% sodium azide and 50% glycerol pH 7.3.
-
Storage instructions
Store at -20℃. DO NOT ALIQUOT
-
Applications
Recommended Dilution:
WB: 1:200-1:2000
IHC: 1:20-1:200
IF: 1:10-1:100
-
Validations

rat brain tissue were subjected to SDS PAGE followed by western blot with Catalog No:113115(NES antibody) at dilution of 1:1000

Immunohistochemical of paraffin-embedded human gliomas using Catalog No:113115(NES antibody) at dilution of 1:50 (under 10x lens)
Immunohistochemical of paraffin-embedded human gliomas using Catalog No:113115(NES antibody) at dilution of 1:50 (under 40x lens)

Immunofluorescent analysis of U-251 cells using Catalog No:113115(Nestin Antibody) at dilution of 1:25 and Alexa Fluor 488-congugated AffiniPure Goat Anti-Rabbit IgG(H+L)
-
Background
Nestin, also named as NES and Nbla00170, is a class VI intermediate filament protein expressed in stem cells of the central nervous system (CNS) but not in mature CNS cells. Its expression is used extensively as a marker for neural lineage cells derived from human embryonic stem (hES) and induced pluripotent stem (iPS) cells. Nestin is also expressed in non-neural stem cell populations such as pancreatic islet progenitors and hematopoietic progenitors.
-
References
- Li M, Sun L, Li Y, Xie C, Wan D, Luo Y. Oxygen glucose deprivation/reperfusion astrocytes promotes primary neural stem/progenitor cell proliferation by releasing high-mobility group box 1. Neurochemical research. 39(8):1440-50. 2014.
- Stoczynska-Fidelus E, Och W, Rieske P. Spontaneous in vitro senescence of glioma cells confirmed by an antibody against IDH1R132H. Anticancer research. 34(6):2859-67. 2014.
- Li M, Sun L, Luo Y, Xie C, Pang Y, Li Y. High-mobility group box 1 released from astrocytes promotes the proliferation of cultured neural stem/progenitor cells. International journal of molecular medicine. 34(3):705-14. 2014.
- Alberton P, Dex S, Popov C, Shukunami C, Schieker M, Docheva D. Loss of tenomodulin results in reduced self-renewal and augmented senescence of tendon stem/progenitor cells. Stem cells and development. 24(5):597-609. 2015.
- Popov C, Burggraf M, Kreja L, Ignatius A, Schieker M, Docheva D. Mechanical stimulation of human tendon stem/progenitor cells results in upregulation of matrix proteins, integrins and MMPs, and activation of p38 and ERK1/2 kinases. BMC molecular biology. 16:6. 2015.
Related Products / Services
Please note: All products are "FOR RESEARCH USE ONLY AND ARE NOT INTENDED FOR DIAGNOSTIC OR THERAPEUTIC USE"
